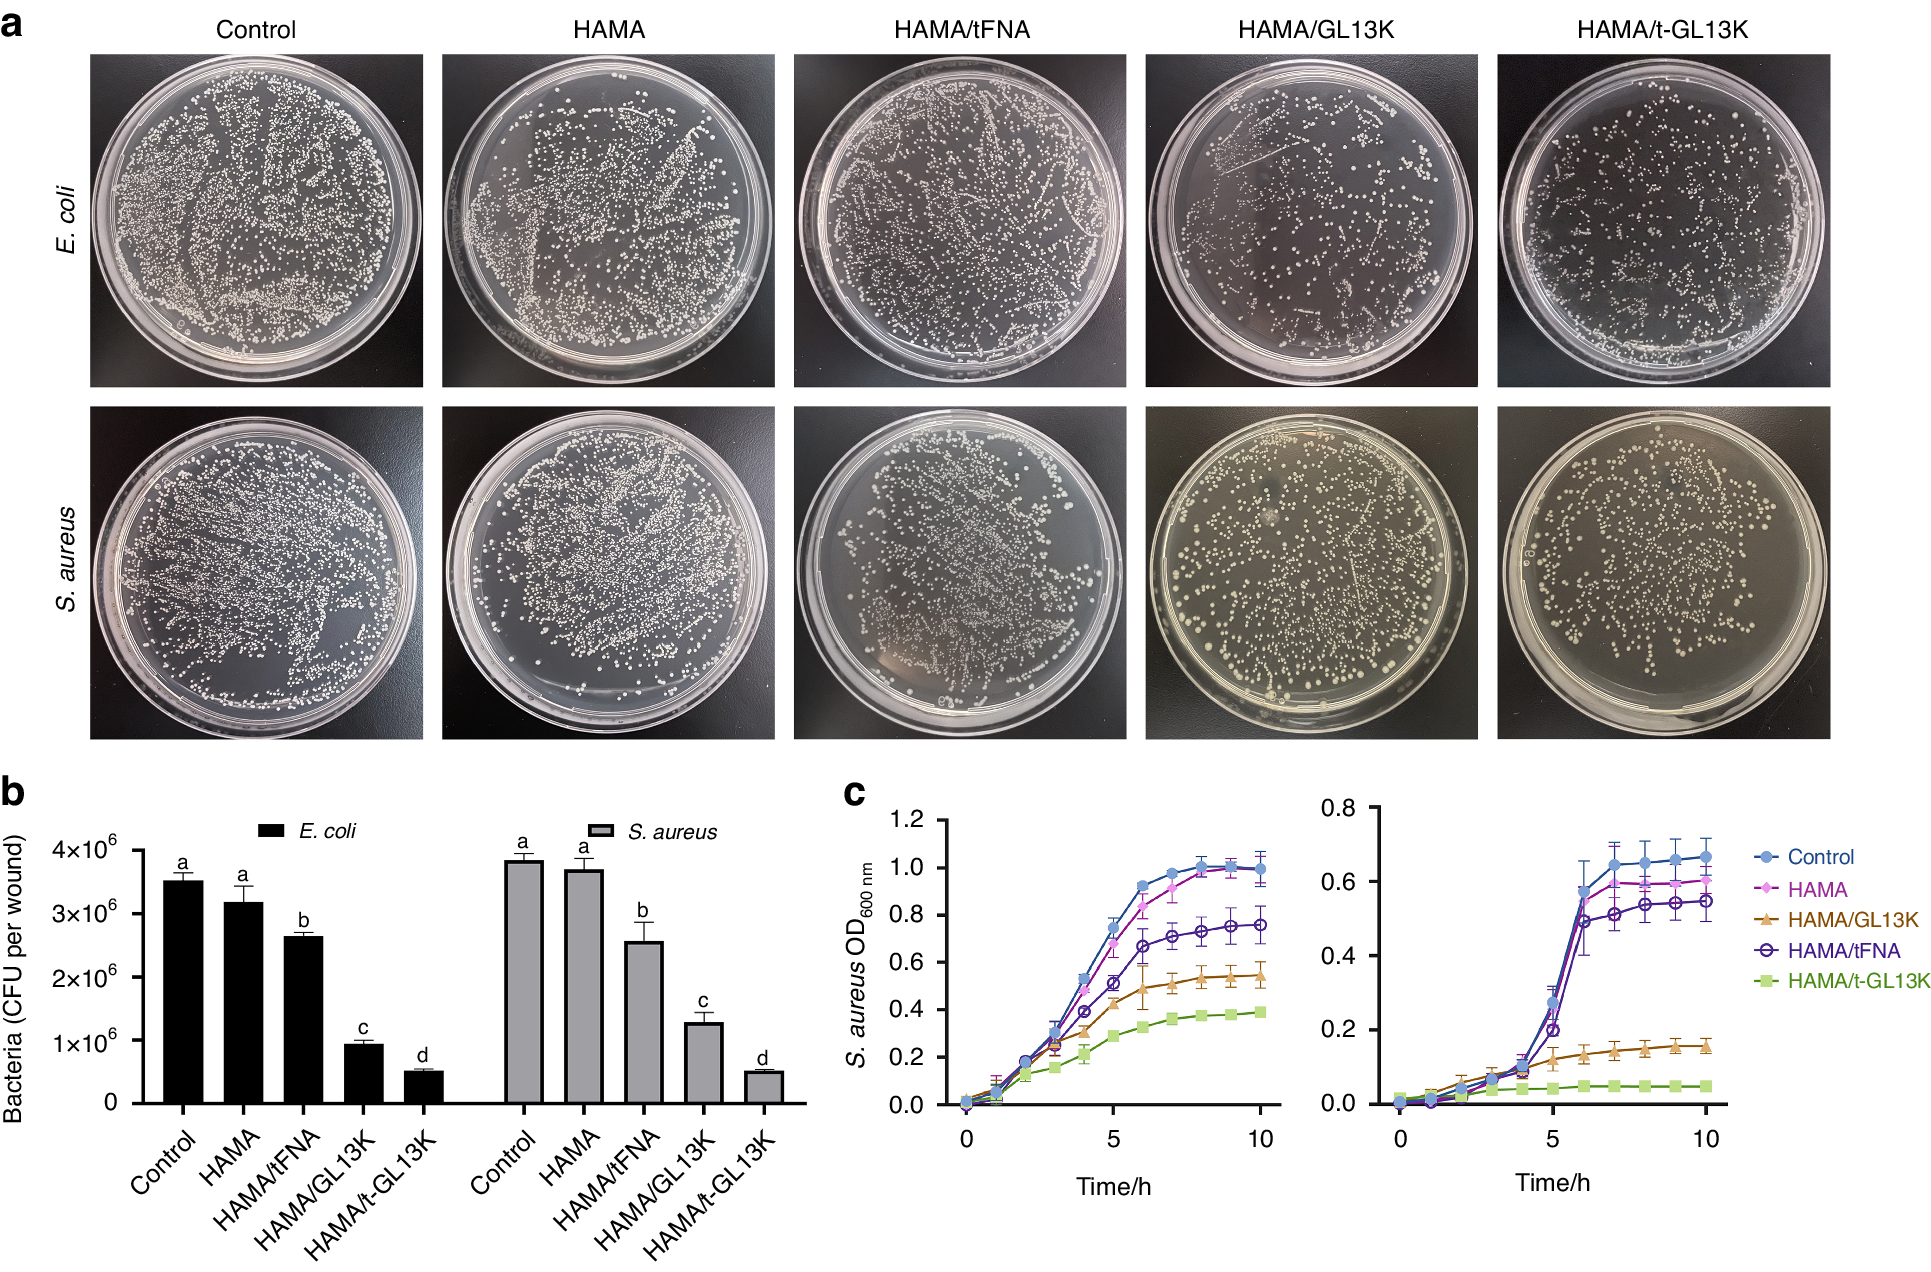
Fig. 2

Fig. 2
Antimicrobial activity of HAMA/tFNA-GL13K hydrogel on E. coli and S. aureus in vitro. a Images of E. coli and S. aureus incubated on agar plates with different hydrogels. b Count bacteria of CFU of E. coli and S. aureus. Superscripts a–d indicate significant differences for CFU between different treatment groups (P < 0.05). c Growth curves of E. coli and S. aureus in different hydrogels treatment. n = 3 independent samples. Data are presented as mean ± SD. Error bars represent SD. T-GL13K is the abbreviation of tFNA-GL13K
